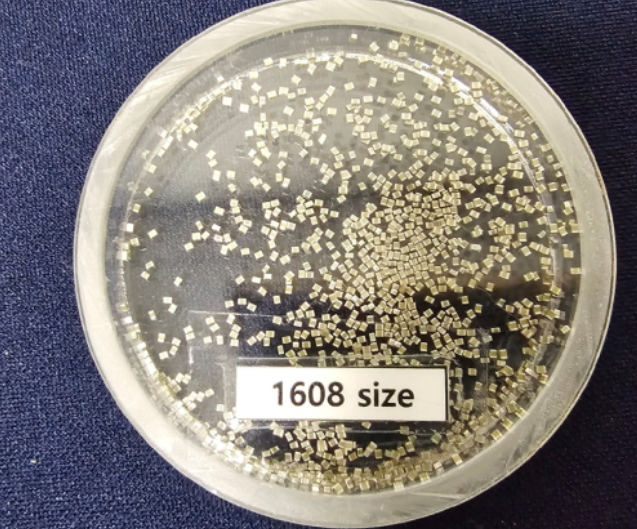

삼성전기가 세계 최대 전기차 업체인 중국 BYD에 적층세라믹커패시터(MLCC)를 대규모로 공급하는 계약을 체결했다. 이번 계약은 이재용 삼성전자 회장의 중국 방문 이후 성사된 것으로, '이재용 세일즈'의 효과라는 평가가 나오고 있다.
MLCC의 중요성
MLCC는 전기를 저장했다가 필요한 만큼 안정적으로 공급하는 핵심 부품으로, 스마트폰, PC, 자동차 등 거의 모든 전자제품에 필수적으로 탑재된다. 자동차에는 동력 전달, 안전, 주행, 인포테인먼트 등 다양한 부품에 최소 3,000개에서 1만개, 전기차에는 최대 1만 8,000개의 MLCC가 탑재된다.
계약 규모 및 의미

삼성전기는 BYD에 수천억 원 규모의 MLCC를 공급할 것으로 알려졌다. BYD는 올해 전기차 약 550만 대를 생산할 계획이어서, 삼성전기가 공급하는 MLCC는 적게는 수십억 개에서 많게는 수백억 개에 달할 것으로 보인다. 특히 이번에 공급하는 MLCC는 첨단운전자지원시스템(ADAS)과 같이 오작동 없이 오래 견뎌야 하는 차량용 부품에 적용되는 것으로 알려졌다. 삼성전기는 이번 수주로 세계 1·2위 전기차 업체(BYD, 테슬라)에 MLCC를 납품하는 기업이 됐다.
이재용 회장의 역할
이재용 회장은 지난 3월 중국을 방문하여 BYD 본사를 방문하고, 왕촨푸 BYD 회장과 전장 부문 협력 방안을 논의했다. 이러한 '총수 외교'가 이번 수주에 긍정적인 영향을 미친 것으로 분석된다.
삼성전기의 전장 사업 확대

삼성전기는 전장용 MLCC를 미래 성장 동력으로 삼고 사업을 확대하고 있다. 장덕현 삼성전기 사장은 "차량 부품사로 이미 체질 개선을 마쳤다"며 전장 사업 확대를 강조한 바 있다. 삼성전기는 올해 전장 및 AI/서버 제품에서 매출 2조 원을 달성하겠다는 목표를 밝혔다.


